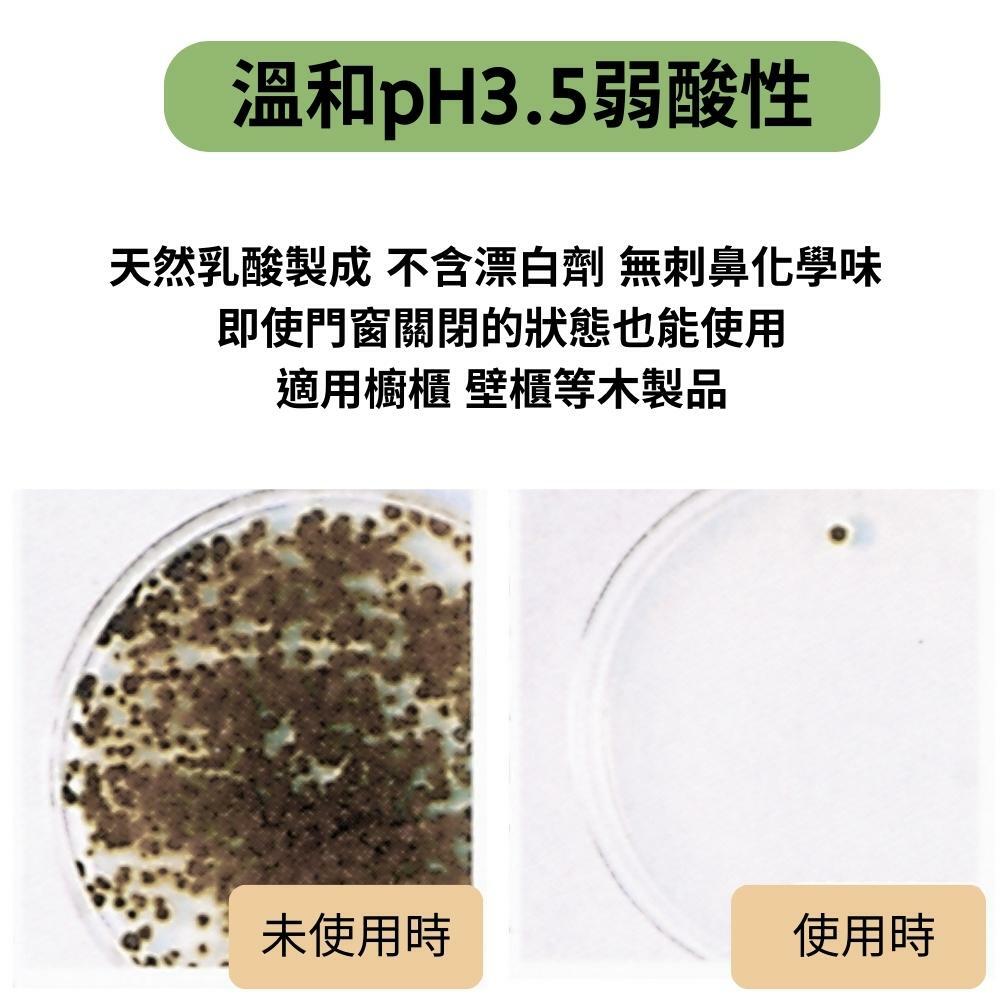

{{ 'fb_in_app_browser_popup.desc' | translate }} {{ 'fb_in_app_browser_popup.copy_link' | translate }}
{{ 'in_app_browser_popup.desc' | translate }}
全店,年中慶 滿千折百
商品存貨不足,未能加入購物車
您所填寫的商品數量超過庫存
{{'products.quick_cart.out_of_number_hint'| translate}}
{{'product.preorder_limit.hint'| translate}}
每筆訂單限購 {{ product.max_order_quantity }} 件
現庫存只剩下 {{ quantityOfStock }} 件
✦產品有任何問題請到官方Line@詢問,會有人員協助您
使用說明
1.噴灑後 靜置約5-10分鐘後使用刷子清潔後清洗擦乾
2.本產品不含漂白成份,對於陳年已久和已浸入的黴菌污漬會比較難去除